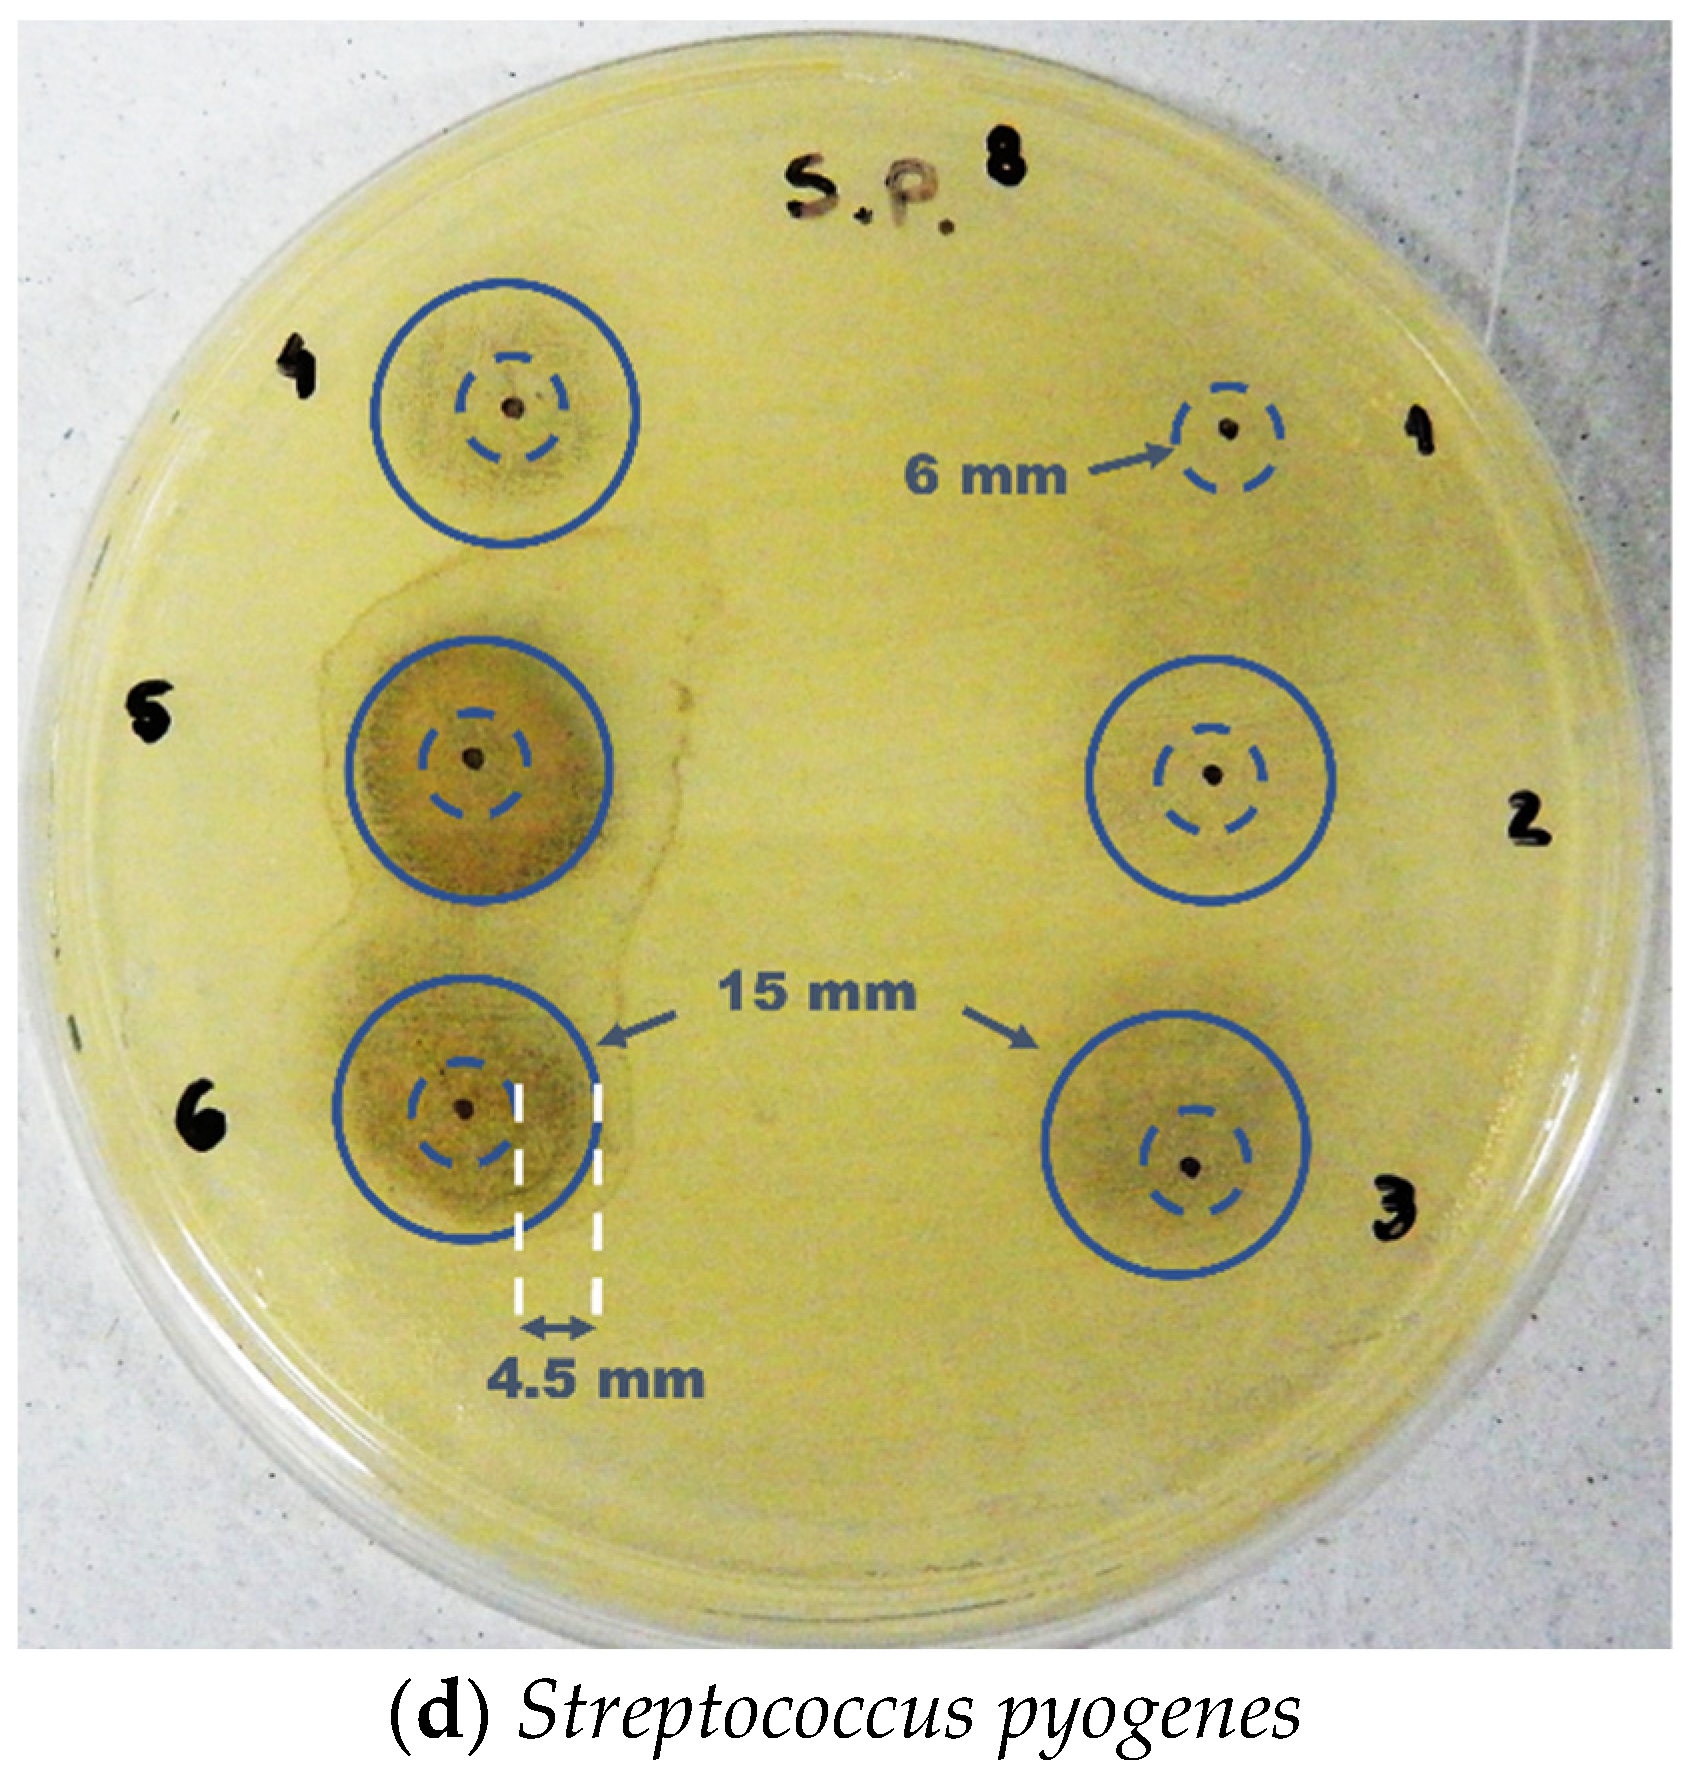
Polymers 14 03588 g012b 550

1. Introduction
Nowadays, mechanical alloying is studied in all materials. It ranges from metals and their alloys to obtaining several composite materials involving metals, polymers, and ceramics to produce various commercial application materials of scientific interest. Among the primary purposes of this technique is to obtain: the formation of alloys in solid state; the possibility of obtaining alloys with immiscible elements by other methods; the refinement of grain size to nanometric levels; the decrease or increase in particle size; particle agglomeration; extension of solubility limits; the development of amorphous phases; and the induction of chemical reactions at low temperature, among others [
1,
2,
3]. Mechanical alloying is a solid–state process that consists of adding the materials to be ground, usually dry, together with the grinding balls inside a jar. The intense impact between the material, the spheres, and the jar walls produce a fine powder with a much higher energy than that of other standard grinding processes [
1,
2]. The application of this technique in polymeric materials is more recent than in other materials, beginning in the late 1980s [
4,
5]. However, in the last decade, the production of polymer matrix composites in several applications has become widely studied [
3,
6,
7,
8,
9,
10]. The mechanisms acting in the polymer mechanical alloying are somewhat different from other materials. There is the possibility of chain breakage during collisions between the samples and the grinding media, leading to a decrease in molar mass. Nevertheless, breaking bonds in the polymeric chains can also lead to free radicals due to fracture processes, providing new chemical bonds and, thus, mixing immiscible polymers in other ways, forming blends without the solvents used [
4,
5,
11,
12,
13,
14,
15]. Furthermore, the crystal structure of semi–crystalline polymers can be altered by milling [
6,
12].
Commonly, polymer matrix nanocomposites require several processing steps, and the processes are slow. Some of them take days to manufacture [
16,
17,
18,
19,
20]. The product’s final volume is usually small, limited by the nature of the process. The sol–gel [
21] and the solution–based, self–assembly (layer–by–layer) methods are highlighted [
22,
23,
24,
25,
26]. The sol–gel method synthesizes materials from the sol system transition to a gel system. The term sol defines a colloidal particle dispersion (sizes between 1 and 100 nm). In contrast, the term gel consists of a system formed by the rigid structure of colloidal particles (colloidal gel) or polymeric chains (polymeric gel), immobilizing the liquid phase inside the interstices [
21,
27]. The solution is the self–assembly (layer–by–layer) technique in a liquid medium, which results in self–structured layers. It consists of the deposition of several layers adhered by the electrostatic attraction between the opposite charges of their constituents. The layers’ deposition is based on physical adsorption, innovating another existing technique based on chemical adsorption [
23,
24,
25,
26].
Comparatively, high–energy ball milling is a solid–state method that does not require additional solvents and all production steps can be made in a dry state. In addition, the only limitation to the bulk material’s production quantity is the jar’s volume. However, there are industrial jars capable of grinding large volumes of material in one run, making mechanical alloying an appealing and possibly viable technological path to obtain polymer matrix composites [
1,
2].
PVA is a synthetic polymer that is thermoplastic, semi–crystalline, non–toxic, biocompatible, biodegradable, hydrophilic, and belons to the polyvinyl ester class. It is commercially available at a low cost, being one of the few water–soluble polymers, depending on the temperature. Its melting temperature is between 180 and 230 °C, depending on the crystallinity degree [
28,
29,
30,
31,
32,
33]. PVA has an excellent ability to form films and hydrogels. In addition, the hydrophilic characteristic of PVA can protect a region from moisture, as it exhibits a high level of absorption of water or biological liquids. Because of this characteristic, PVA can form films with several functionalities, including simulating a natural tissue, enabling numerous applications in biological materials [
28,
32,
33,
34]. Silver (Ag) has been used due to its potent antimicrobial activity properties against various types of pathogens, especially in recent times due to the emergence of resistant bacteria [
35,
36,
37,
38,
39,
40,
41,
42,
43,
44,
45]. Furthermore, when it is combined with PVA, a biocompatible and biodegradable polymer, it is possible to obtain a polymeric film, resistant to microbial contamination, ideal to create films for potential application as biomaterials [
34,
46,
47,
48,
49]. The originality of this work lies in the use of mechanical alloying in the production of the PVA/Ag composite, which has proved to be a promising processing path. This powder can be easily formed to produce bacterial growth–inhibiting films. Such films can be used both in biocompatible functions and in other applications that require the absence of microorganisms.
The present work is aimed at studying the feasibility of using mechanical alloying to obtain a composite material with an ultrafine dispersion of Ag particles in a PVA matrix using an Attritor mill, with subsequent evaluation of the antimicrobial activity of the obtained materials.
2. Materials and Methods
The materials used in this research were:
Silver nitrate (AgNO3)—in powder form, white, supplied by the company Sigma–Aldrich, Saint Louis, MO, USA. It has a silver content of 63.35% and 99.98% purity.
Poly(vinyl alcohol) (PVA)—in the form of a white, odorless granular powder, supplied by the Chemical Company, Jamestown, RI, USA, with an approximate molar mass of 72 × 103 g mol−1 and a hydrolysis degree of 88.09%.
Sodium hydroxide (NaOH) in powder form, white, supplied by the company Sigma–Aldrich, Saint Louis, MO, USA with an approximate molar mass of 40 g mol−1.
Formaldehyde (HCOH) supplied by Dinâmica Química Contemporânea LTDA, Indaiatuba, SP, BRA, with an approximate molar mass of 30.03 g mol−1.
In this research, obtaining Ag was possible by using consecutive oxidation reactions and reduction of silver nitrate [
50,
51]. Mechanical alloying was used to homogeneously disperse the Ag particles in the polymeric matrix. With the obtained dispersion, films were produced by the widely used hot pressing method [
52,
53]. The samples were characterized by X-ray diffraction, optical microscopy, scanning electron microscopy by field emission electron gun
(SEM–FEG), and differential and infrared exploratory calorimetry (
DSC and
FTIR) analysis.
2.1. Chemical Reactions to Obtain Silver
Firstly, a 250 mL of sodium hydroxide solution (NaOH) with a concentration of 1 molar was prepared in a volumetric flask. Afterwards, 10 g of white silver nitrate (AgNO3) was weighed in a beaker. The NaOH solution was subsequently added to the beaker with the AgNO3 and kept at 80 °C on a Solab magnetic stirrer with a heating plate (model SL–91) to homogenize the solution and accelerate the reaction for forming black–colored silver oxide (Ag2O), according to Equation (1). After 40 min under the conditions described, the heating plate was switched off. The resulting residue was placed on filter paper, washed in distilled water several times to remove residues from the solution, and dried to perform X-ray diffraction and SEM–FEG analysis of Ag2O. After that, the Ag2O formation experiment was repeated, and about 10 mL of formaldehyde (HCOH) was slowly pipetted for the formation of yellowish silver (Ag) to occur (as it is unpolished), with some metallic shine points according to Equation (2). The resulting residue was also placed on filter paper, successively, and several rounds of rinsing was conducted followed by oven drying to perform an X-ray diffraction and an SEM–FEG analysis of Ag.
The expected reactions were as follows:
The filtering was performed in a device connected to a vacuum pump and later placed in an oven at 40 °C for 24 h for drying purposes. Afterwards, they were photographed, and their visual aspects compared with the as–received sample.
2.2. X-ray Diffraction of Silver Nitrate, Silver Oxide, and Silver
The characterization was performed in a Rigaku Diffractometer, model Ultima IV, using Cu–Kα radiation (0.154 nm). The equipment is installed in the Multi–User Laboratory (C—LABMU) of the State University of Ponta Grossa. The scanning ranges (diffraction angle 2θ) were from 20 to 90° in the step scan mode, with a step of 0.02° and 5 s at each point.
2.3. SEM–FEG of Silver Nitrate, Silver Oxide, Silver, and PVA
The samples were metalized with a gold and palladium alloy to avoid electrical charging before being placed into the microscope. The metalizing equipment used is from Qorum Sputter Coater, model SC7620. An SEM–FEG characterization was performed using Tescan equipment, model Mira. Both equipament are installed in the Multi–User Laboratory (C—LABMU) of the State University of Ponta Grossa. To obtain pure PVA, AgNO3, or composite PVA/Ag images, the SEM–FEG was operated between 3 and 5 kV, although 15 kV for Ag and Ag2O, using secondary electrons in all cases. The low voltage for AgNO3 and the polymer matrix was chosen because higher voltages cause charging and damage to these types of materials, respectively.
2.4. Commercial PVA Mechanical Alloying and SEM–FEG of Samples
The commercial PVA samples were processed with high–energy ball milling in a Union Process Attritor mill, model Attritor 01 HD, installed at the Department of Materials Engineering at the State University of Ponta Grossa. The milling balls used were made of zirconia with a 6.35 mm diameter size. The use of this type of ball instead of steel balls was to minimize contamination with traces of metal. For this same reason, the jar and milling rod used were made of ultra–high molar mass polyethylene, while the rod arms were made of zirconia. Running water at room temperature cooled the mill; thus the heat generated by the grinding action would be dissipated, avoiding possible thermal degradation of the polymer. The milling power adopted in this work was 38:1 for all milling performed. The speed rotation was 600 rpm. The milling parameters are summarized in
Table 1 while the PVA milling times are described in
Table 2:
After that, SEM–FEG sampling was performed with the same parameters and procedures indicated in the previous item, to verify the influence of milling on the size and morphology of the polymer particles.
2.5. Differential Scanning Calorimetry (DSC) Analysis Processed in an Attritor–Type Mill
The
DSC analyses were performed using Setaram equipment, Labsys model, installed in the Multi–User Laboratory (C—LABMU) of the State University of Ponta Grossa, with a thermal analysis capacity of up to 1600 °C. The analysis was conducted in an argon atmosphere with a 20 mL/minute flow in an alumina crucible with approximately 30 mg of material. The heating and cooling rates were 10 °C/minute. The scanning range was from 20 °C to 230 °C, performed in a single cycle. This characterization was intended to verify the influence of different milling times on the melting temperature of the PVA, comparing it with the as–received material, as shown in
Table 2.
2.6. Mixing of Several Amounts of PVA and Ag by Mechanical Alloying and Infrared Spectrophotometry Assay with Fourier Transform (FTIR) Analyses of the Mixtures
Some Ag dispersions were prepared in a PVA matrix, where the Ag was obtained by oxidation reactions and reduction of AgNO
3. These mixtures were conducted in the same high–energy ball mill used to mill commercially pure PVA. Preliminary experiments were performed, such as milling together the Ag and the PVA from the beginning for 2 and 4 h. Another attempt was made to mill the PVA alone for 1 h, stopping the milling and adding the Ag and milling for another 1 h. Under these conditions, there were still many non–adhered and unsatisfactorily dispersed Ag particles on the polymer matrix. Therefore, all of these parameters were discarded. Based on the preliminary results,
DSC and
SEM–FEG analyses, the milling time to mixing PVA and Ag chosen was 4 h, while the milling parameters were the same as from
Table 1.
The procedure to obtain the Ag dispersion in the matrix was to mill the commercially pure PVA for 2 h, followed by an interruption of the milling and mixing of the Ag with the previously ground PVA, and the finalization of the Ag milling process for another 2 h. In this way, the best relation between the PVA milling time and Ag dispersion in the matrix of the mill operation was achieved.
Milling products with different mass concentrations of Ag weighed on an analytical balance with a mass/mass ratio were elaborated for further characterization and verification of the metal effects in the matrix. The mass fractions used in this work compared with the as–received PVA are shown in
Table 3.
After that, the
FTIR analysis was conducted using SHIMADZU equipment, model IR Prestige–21, and 64 scans/min, resolution of 4 cm
−1, installed in the Multi–User Laboratory (C—LABMU) of the State University of Ponta Grossa. The samples analyzed were as–received PVA (A), pure PVA milled for 4 h (E) from
Table 2, and powdered mixture PVA with Ag particles, from
Table 3 (E1 to E5).
The powder samples were prepared via cold pressing using a SHIMADZU manual hydraulic press, installed in the Multi–User Laboratory (C—LABMU) of the State University of Ponta Grossa. These disks were set as the sample mixture to be analyzed with potassium bromide (KBr) from the Vetec, each 5 and 195 mg. A reference reading was performed with a pure KBr disk.
2.7. Preparation of Polymeric Films from the PVA/Ag Mixture by Hot Pressing and Characterization by Transmitted Light Optical Microscopy
In this step, for each sample condition, films were made via hot pressing in a Schwing Siwa manual hydraulic press, model 30 tons, installed at the Department of Materials Engineering at the State University of Ponta Grossa. After several tests, the film with a more homogeneous aspect was obtained by processing at a temperature of 220 °C. Then, the press was heated to 220 °C with a thermocouple control. The films were produced with 2 g of material, resulting in a close to circular shape, 3 mm thickness, and 70 mm in diameter. The samples used to prepare films were as–received PVA (A), pure PVA milled for 4 h (E) from
Table 2, and powdered mixture PVA with Ag particles, from
Table 3 (E1 to E5).
After obtaining the films, they were characterized by transmitted light microscopy to assess the distribution of Ag particles on the PVA surface. The equipment used was an Olympus optical microscope, model BX–51, installed at the Department of Materials Engineering of State University of Ponta Grossa, with a digital camera coupled and controlled by software Image–Pro Plus, version 5.1, from Media Cybernetics Inc., Rockville, MD, USA.
2.8. Characterization of the Fracture Surface of the Films by SEM–FEG
The films produced underwent a process of embrittlement in liquid nitrogen inside a Styrofoam container. This bath was maintained for approximately 5 min to weaken the sample and facilitate fracture, performed with standard pliers. The pieces were then metalized to produce a conductive barrier. Thus, the fracture surfaces along the thickness can be analyzed by SEM–FEG, mainly the distribution of Ag particles.
2.9. Chemical Microanalysis of Particles by Energy Dispersion (EDS)
A chemical microanalysis was conducted using an EDS coupled to the SEM–FEG equipment, device installed in the Multi–User Laboratory (C—LABMU) of the State University of Ponta Grossa. The equipment used was mentioned in the topic above. This analysis was performed to estimate the presence of Ag in the thickness of the fragile film.
2.10. Microbiological Sensitivity Tests on Polymeric Films
The antibiogram, also known as the Antimicrobial Susceptibility Test (
AST), is an in–vitro assay that measures the susceptibility or resistance of bacteria to antimicrobials. The method used in this work was susceptibility in a culture plate (90 mm in diameter and 15 mm high) on Müeller Hinton agar. This medium contains proteins and carbohydrates that provide the ideal substrate for developing and growing bacterial strains of interest. This test was conducted to evaluate the antimicrobial activity of polymeric films [
42,
43,
45,
46,
49,
54] and it was performed at Department of Pharmacy and Biochemistry at the State University of Ponta Grossa. The analyzed samples are shown in
Table 4.
The tests were conducted using bacterial strains provided by the American Type Culture Collection (ATCC). They are:
- ✓
Escherichia coli—ATCC 0022;
- ✓
Staphylococcus aureus—ATCC 0023;
- ✓
Streptococcus pyogenes—ATCC 0015;
- ✓
Pseudomonas aeruginosa—ATCC 0016.
The bacterial suspensions were prepared by adding some microorganism colonies in a sterile saline solution. Afterwards, the suspension was read until a turbidity of 1.5, McFarland scale (approximately 108 CFU/mL), was achieved on a Biosystems spectrophotometer, model BTS–330. This procedure was performed individually for each studied bacterium [
32,
35,
37,
41,
42,
44,
45,
46,
47,
48,
49,
50,
54,
55].
At that moment, each bacterial suspension was sown with the aid of a sterile swab in a culture dish. Then, 6 mm diameter polymeric film discs were deposited and dispersed on the seeded plates. These plates were incubated in a QUIMIS microbiological oven, model Q316M4, at 36 °C for 24 h. Subsequently, the plates were observed to identify the presence or absence of a bacterial inhibition halo in the culture medium. The bacteria growth inhibition halo
(H) was measured according to Equation (3) [
46], as follows:
where
D is the diameter of the zone of inhibition and
d is the diameter of the PVA film disc containing Ag particles.
4. Conclusions
Based on the results discussions, it can be concluded that:
X-ray diffraction measurements showed that it was possible to obtain Ag2O from the oxidation of AgNO3 with 1 molar NaOH solution and subsequently obtain Ag by reducing Ag2O with formaldehyde. In addition, SEM–FEG measurements showed that many of these Ag2O and Ag particles were ultrafine, measuring between 200 and 400 nanometers.
It was observed that the mechanical alloying promoted significant refinement and a morphology change in the PVA particles, changing in shape close to the equiaxial of the as–received material to fine flakes after milling. The milling proved to be a promising path to follow for distributing Ag in the PVA matrix in a homogeneous manner throughout the thickness of the polymeric film.
The agar antimicrobial susceptibility test evaluated the films produced. It was observed that there was no inhibition of microbial activity in pure PVA. The inhibition was verified on the surface of all the films that had Ag particles and for all the bacteria tested.